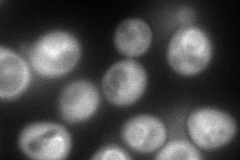

View description
Karyopherin alpha homolog, forms a dimer with karyopherin beta Kap95p to mediate import of nuclear proteins, binds the nuclear localization signal of the substrate during import; may also play a role in regulation of protein degradation
Localization:
Intensity:
Fold change:
Significance:
-
C’ GFP library in SD

below threshold19.1 -
N' NOP1pr-GFP in SD
cytosol,punctate,nuclear periphery158.059 -
N' TEF2pr-mCherry in SD

missing0 -
N' NATIVEpr-GFP in SD

missing0 -
N' TEF2pr-VC and Cyto-VN in SD

#N/A0 -
C’ GFP library in SD+DTT

cytosol17.780.93No -
C’ GFP library in SD+H2O2

cytosol18.710.97No -
C’ GFP library in Starvation Media

cytosol15.920.83No -
C’ GFP library on the background of Pup2-DaMP

below threshold -
C’ GFP library on the background of CCT mutant

below threshold19.67211.02917No
